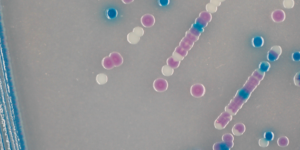

微生物検査
あらゆる微生物の検査をトータルでサポート
関東化学では、病院での臨床微生物検査や食品・環境の衛生検査などでお使い頂ける粉末培地や生培地をはじめ、精度管理に必要不可欠な標準菌株や薬剤耐性菌のスクリーニング用培地、分子疫学解析や遺伝子検出用のPCRキットなど、幅広い製品ラインナップを取りそろえております。
微生物検査でお困りのことがございましたら、関東化学までご相談ください。
製品分野・菌種別カテゴリー
用途別カテゴリー
「シカジーニアス®分子疫学解析POTキット」、「シカジーニアス®薬剤耐性菌・病原因子関連PCRキット」は下記のページをご参照ください。
●シカジーニアス®分子疫学解析POTキット
●シカジーニアス®薬剤耐性菌・病原因子関連PCRキット
微生物検査に関する
お問い合わせ
メールでのお問い合わせ
お電話でのお問い合わせ